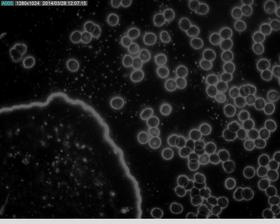

naturopat
28. mar 2014
Ťažké kovy
Bývate v Bratislave, nebodaj blízko Slovnaftu alebo vonkajšieho diaľničného okruhu? Potom sa Vás ťažké kovy určite týkajú. Zoznam prejavov toxikácie je dlhý, na začiatku je to chronická únava, narušená funkcia štítnej žľazy, pečene, žlčníka, obličiek....a potom možno aj psychické poruchy.